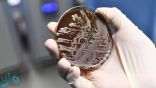

أرشيف الوسم : البكتيريا
“الغذاء والدواء”: ثلاثة أنواع من البكتيريا تهدد سلامة الغذاء
وصلة دائمة لهذا المحتوى : https://www.mnbr.news/434409.html
لاحتوائها على نسبة عالية من البكتيريا والفطريات .. “الغذاء والدواء” تحذّر من 5 منتجات حناء
وصلة دائمة لهذا المحتوى : https://www.mnbr.news/231936.html
الكشف عن تفاصيل أول هاتف ذكي في العالم مضاد للبكتيريا
وصلة دائمة لهذا المحتوى : https://www.mnbr.news/231202.html
مادة غذائية تحسن عمل الأمعاء.. تعرف عليها
وصلة دائمة لهذا المحتوى : https://www.mnbr.news/228953.html
اكتشاف بكتيريا جديدة قادرة على تفكيك النفايات البلاستيكية
وصلة دائمة لهذا المحتوى : https://www.mnbr.news/206320.html
4 نصائح مهمة لتفادي تكوّن البكتيريا والعفن بـ«الغسالات»
وصلة دائمة لهذا المحتوى : https://www.mnbr.news/182888.html
هكذا تتخفى البكتيريا لـ”خداع” مضادات الالتهاب
وصلة دائمة لهذا المحتوى : https://www.mnbr.news/160587.html
“الغذاء والدواء” تحذّر من بودرة دهن عود لاحتوائها على نسبة عالية من البكتيريا
وصلة دائمة لهذا المحتوى : https://www.mnbr.news/149823.html
اسباب مقاومة البكتيريا للمضادات الحيوية
وصلة دائمة لهذا المحتوى : https://www.mnbr.news/130009.html
“الغذاء والدواء” تحذّر من نوع لـ”بودرة تالك” لاحتوائها على نسبة عالية من البكتيريا
وصلة دائمة لهذا المحتوى : https://www.mnbr.news/129790.html
“البكتيريا الخارقة” تقاوم المطهرات الكحولية وتنذر بالخطر
وصلة دائمة لهذا المحتوى : https://www.mnbr.news/93575.html
تطوير فيروس قادر على قتل البكتيريا
وصلة دائمة لهذا المحتوى : https://www.mnbr.news/69621.html
باحثون: الميكروبات تتناثر في الهواء بشكل واسع بفعل الأمطار
وصلة دائمة لهذا المحتوى : https://www.mnbr.news/24003.html